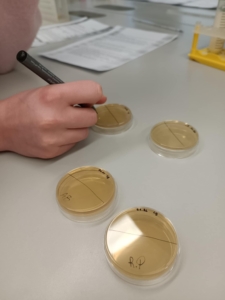

Sausio 29-oji mūsų gimnazistams tapo diena, kai mokykliniai projektai persikėlė į tikrą universiteto pasaulį. 38 II–III klasių mokiniai kartu su 5 mokytojais išvyko į Vilnių dalyvauti VGTU programos „Ateities inžinerija“ kūrybinėse dirbtuvėse – ten jų laukė praktika, konsultacijos ir pažintis su akademine aplinka.
Universitete vyko keturių krypčių dirbtuvės: „Mikroorganizmai biotechnologijose“, „Mobilioji programėlė“, „Išmanusis šiltnamis“ ir „Žalioji energetika“. Mokiniai dirbo su savo projektais, konsultavosi su dėstytojais ir gilinosi į pasirinktas temas. „Mikroorganizmai biotechnologijose“ grupės dalyviai turėjo išskirtinę galimybę dirbti moderniose laboratorijose – jie atliko tyrimus, analizavo pieną ir jo rūgštis, susipažino su realiais moksliniais metodais.
Kitų tematikų dalyviai jungėsi į nuotolines konsultacijas su savo sričių vadovais. Mokiniai pristatė vystomus projektus, aptarė jų eigą, gavo konkrečių patarimų ir rekomendacijų tolimesniam darbui. Tokios konsultacijos padėjo aiškiau suprasti projektų kryptį ir sustiprino pasitikėjimą savo idėjomis.
Išvyka tapo vertinga patirtimi: gimnazistai ne tik pagilino žinias, bet ir pajuto, kaip atrodo tikras projektinis darbas universiteto lygmeniu. Tai buvo diena, kuri sustiprino motyvaciją kurti, tyrinėti ir drąsiau planuoti savo ateities studijas.